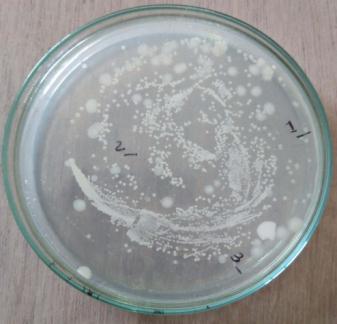
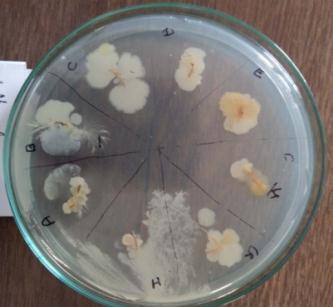
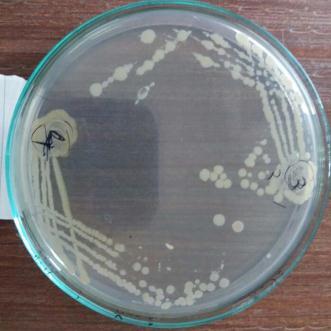
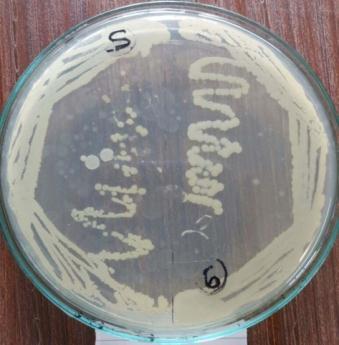
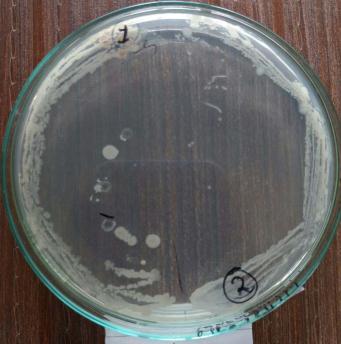

ISOLATION AND CHARACTERIZATION OF POTENTIAL PLANT GROWTH PROMOTING MICROBES ISOLATED FROM TRITICUM AESTIVUM L.
RHIZOSPHERE AND ENDOPHYTES
Monaliben Pansuriya1
1B.Sc. Agriculture Biotechnology, Navsari Agricultural University, Surat, India ***

Abstract - In the present study, samples of rhizosphere and not nodules were collected from the farm of Kosad village, Amroli, Surat of Gujarat to isolate plant growth promoting microbial consortium. Plans-bacterial interactions in the rhizosphere are complex and determine the plant health, productivity, and soil fertility. One of the most promising potential isolates exhibiting organic acid was identified as Bacillus cereus strain MWS5 and bacillus flexus strain MWR3 based on the Morphological, biochemical characterization. The isolates were initially screened based on the seed germination assay for their plant growth promoting traits The results indicated that Bacillus cereus strain MWS5 and bacillus flexus strain MWR3 were significant potential when applied to germinated mungbean seed to uncover its efficacy as effective PGPR.
Key Words: Wheat field, identification of isolates, PGPR, morphologicalandbiochemicalcharacterization,pottrial
1.INTRODUCTION
Table -1: Taxonomicalclassificationofwheat:
Kingdom Planate
Subkingdom Tracheobionta
Superdivision Spermatophyta
Division Magnoliophyta
Class Liliopsida
Subclass Commelinidae
Order cyperales
Family Poaceae
Genus Triticum
Species Aestivum L.
Wheatisagrasswidelycultivatedforitsseed,acerealgrain whichisaworldwidestaplefood.Therearemanyspeciesof wheatwhichtogethermakeupthegenusTriticum;themost widelygrowniscommonwheat(T. aestivum).
Globally, wheat is the leading source of vegetal protein in humanfood,havingaproteincontentofabout13%,whichis relativelyhighcomparedtoothermajorcerealsandstaple foods.In100grams,wheatprovides327caloriesandisarich sourceofmultipleessentialnutrients,suchasprotein,dietary fiber,manganese,phosphorus,andniacin.SeveralBvitamins andotherdietarymineralsareinsignificantcontent.Wheatis 13% water, 71% carbohydrates, and 1.5% fat. Its 13% proteincontentiscomprisedmostlyofglutenas75-80%of totalwheatprotein,whichupondigestion,contributesamino acidsforhumannutrition.
Thecultivationofwheatdatestomorethan5000yearsback duringtheeraofIndusvalleycivilizationwheretheoriginal species was Triticum Sphaerococcum popularly known as Indianwheathasnowdisappearedandreplacedbypresent dayspecies- Triticum aestivum orthecommonBreadWheat. Triticum durum or the Macaroni wheat and the Triticum dicoccumortheEmmerWheat.
Currently,IndiaissecondlargestproducerofWheatinthe worldafterChinawithabout12%shareintotalworldWheat production.Now,Indiaissurplusand,inaposition,toexport Wheat in the International Market and can earn foreign exchange.Indiahasexportedabout30lakhtonnesofWheat worthRs.1.490croreduring2001-02.
ThreespeciesofWheatnamely,(i) T. aestivum,(ii) T. durum and(iii) T. dicoccum arebeingcultivatedinthecountry,as perdetailsgivenasunder:
Table -2: Cultivatedareaofwheatinindia
Uttar Pradesh, Punjab, Haryana. Rajasthan, Bihar, West Bengal, Assam,PartsofMadhya Pradesh, Himachal Pradesh, Jammu & Kashmir
Madhya Pradesh, Maharashtra, Gujarat, SouthernRajasthan,and fewlocationsinPunjab
3 T. dicoccum 1% Karnataka, Maharashtra &TamilNadu
The total area under Wheatin the worldisaround 225.62 millionha,withaproductionof685.6milliontonnes(200910).ThemajorWheatproducingcountriesareChina,India, USA,France,Russia,Canada,Australia,Pakistan,Turkey,UK. Argentina,Iran,andItaly.Thesecountriescontributeabout 76%ofthetotalworldWheatproduction.
Chemical fertilizers are generally used to supply essential nutrients to the soil- plant system throughout the world. However, the prices, availability, and the environmental concernsofchemicalfertilizersespeciallytheNfertilizersare real issues of today's agriculture. Application of chemical fertilizersinsloppinglandscapesunderhighannualrainfall normallyexistinthemountainecosystemoftheHinduKush Himalayan (HKH) region may not be effective because of surface runoff and leaching. Therefore, there is an urgent need to find alternative strategies that can ensure competitivecropyields,provideenvironmentalsafety,and protection while maintain long term ecological balance in agro-ecosystem.Useofmicrobialinoculantsorplantgrowthpromoting rhizobateria (PGPR) for the enhancement of sustainable agricultural production is becoming a more widely accepted practice in intensive agriculture in many partsoftheworld.
and/or other nutrients (Glick, 1995; Jeon et al., 2003): (d) antagonisticeffectagainstphytopathogenicmicroorganisms byproductionofsiderophores,thesynthesisofantibiotics, enzymes, and/or fungicidal compounds, and competition withdetrimentalmicroorganisms(Deyetal.,2004;Lucyetal., 2004).
Keepinginmidthestudywasplannedtoisolatethenative strains from rhizosphere and endo-rhizosphere of wheat grownondifferentsoils.Thesebacteriawerecharacterized andInteractionofpotentialorganicacidproducingmicrobes (plantgrowthpromotingmicrobes)withmoungbeanseed.
1.2 Objective:
1. Isolationandcharacterizationofpotentialplantgrowth promoting microbes isolated from triticum aestivum L. rhizosphereandendophytes.
2. Morphological and biochemical characterization of potentialplantgrowthpromotingmicrobes.

3. Interactionofpotentialorganicacidproducingmicrobes (plant growth promoting microbes) with moungbean seed.
2. REVIEW OF LITERATURE
Plants and microbes can have a variety of interactions including pathogenic,symbiotic, and associative- all which impact plant productivity, stress tolerance and disease resistance. Beneficial symbiotic relationships between legumesandnitrogen-fixingmicrobialsymbiontshavebeen recognizedby (Bergersen 1971) andhavethedetrimental effectsofplantpathogensoncrops (Oerke 2006)
Asidefromtheeffectsofspecificpathogensandsymbiontson planthealth,recentresearchdoneby (Mendes et al. 2011; Panke-Buisse et al. 2015) indicatedthatthecompositionof microbial communities at roots, the so-called root microbiome, can have significant impacts both on plant developmentandtheirstresstolerance.
Plant growth-promoting rhizobacteria are free-living soil bacteria that aggressively colonize the rhizosphere/plant roots, and enhance the growth, and yield of plants when applied to seed or crops (Kumar et al., 2014). The plant growth promoting (PGP) effect of the PGPR is mostly explainedbythereleaseofmetabolitesdirectlystimulating growth.Severalmechanismshavebeenpostulatedtoexplain howPGPRbenefitthehostplant.Theseinclude:(a)theability toproduceplantgrowthregulatorsorphytohormonessuch asindoleaceticacid(IAA),cytokinins,andgibberellins(Glick, 1995; Marques et al.,2010): (b)enhancing asymbiotic N2 fixation(Sahin et al., 2004; Khan,2005); (c) solubilizing inorganicphosphateandmineralizationoforganicphosphate

Further, inoculation by different members of the plant microbiome may differentially alter plant phenotype (Zamioudis et al., 2013; Timm et al., 2016).Thepresence of unique bacterial strains in legume genotypes explained more variation in shoot biomass root biomass, and plant height than plant genotype did (Tan & Tan, 1986) Inoculationofcommonendophytescanalsoinhibitprimary rootelongationandpromotelateralrootformationandroot hair production (Zamioudis et al., 2013; Weston et al., 2012)
Plant growth-promoting rhizobacteria are free-living soil bacteria that aggressively colonize the rhizosphere/plant roots, and enhance the growth, and yield of plants when appliedtoseedorcrops. (Kumar et al., 2014).
The ability to produce plant growth regulators or phytohormonessuchasindoleaceticacid(IAA),cytokinin, and gibberellins (Glick, 1995; Marques et al., 2010); (b) enhancingasymbioticN2fixation (Sahin et al., 2004; Khan, 2005); (c) solubilizing inorganic phosphate and mineralizationoforganicphosphateand/orothernutrients (Glick, 1995; Jeon et al., 2003); (d) antagonistic effect againstphytopathogenic microorganismsbyproductionof siderophores,thesynthesisofantibiotics,enzymes,and/or fungicidal compounds, and competition with detrimental microorganisms (Dey et al., 2004; Lucy et al., 2004)
Interest in the beneficial rhizobacteria associated with cereals has increased recently and several studies clearly demonstratedthepositiveandbeneficialeffectsofPGPRon growth and yield of different crops especially wheat at differentenvironmentundervariableecologicalconditions (Ozturk et al., 2003; Marques et al., 2010; Mehnaz et al., 2010; Zhang et al., 2012)

Inoculation with Pseudomonas fluorescens showed a significantincreaseinrootweight19-43%,numberoftillers perplant10-21%,grainyield15-43%,andstrawyield2239% of wheat compared to un-inoculated plants (Shaharoona et al.,2008).Moreover,inoculationwithPGPR strainAzotobactersaved25-30kgNha-1chemicalfertilizer (Narula et al., 2005).
Morerecently, Kumar et al. (2014) conductedexperiments onwheatunderpotandfieldconditiontoexaminetheeffect ofPGPRSonthegrowthandyieldofwheatandfoundthat triple combination of strains B. megaterium, A. chlorophenolicus,andEnterobactersignificantlyincreased 17.5,79.8,78.6,and 26.7%plant height, grainyield,straw yield,andtestweightunderpotconditionandalso29.4,27.5, 29.5, and 17.6% under field condition, respectively. Knowledge of the native bacterial population, their characterization, and identification is required for understandingthedistributionanddiversityofindigenous bacteriaintherhizosphereofspecificcrops (Keating et al., 1995; Chahboune et al., 2011).
With increasing awareness about the-chemical-fertilizers based agricultural practices, it is important to search for region specific microbial strains which can be used as a growthpromoting/enhancinginoculumtoachievedesired cropproduction (Deepa et al., 2010)
Colonymorphology,size,colour,shape,gumproduction,and growth pattern were recorded after 24 h of growth on LB agarplatesat28±2°Casdescribedby Somasegaran and Hoben (1994).Basedoncellandcolonymorphology,nine differentmorphotypeswereidentifiedfromrhizosphereand endosphereofwheat.Thesemorphotypesweresubjectedto restriction fragment length polymorphism of IGS to distinguishamongthesegenotypes
Alternatively, Somers et al. (2004) classifiedPGPRbasedon theirfunctionalactivitiesas(i)biofertilizers(increasingthe availabilityofnutrientstoplant),(ii)phytostimulators(plant growthpromotion,generallythroughphytohormones),(iii) rhizoremediators (degrading organic pollutants) and (iv) biopesticides(controllingdiseases,mainlybytheproduction of antibiotics and antifungal metabolites) (Antoun and Prévost, 2005).Furthermore,inmoststudiedcases,asingle PGPR will often reveal multiple modes of action including biological control (Kloepper, 2003; Vessey, 2003) Furthermore, Gray and Smith (2005) haverecentlyshown thatthePGPRassociationsrangeinthedegreeofbacterial proximitytotherootandintimacyofassociation.Ingeneral, thesecanbeseparatedintoextracellular(ePGPR),existingin therhizosphere,ontherhizoplane,orinthespacesbetween cellsoftherootcortex,andintracellular(iPGPR),whichexist insiderootcells,generallyinspecializednodularstructures (Figueiredo et al., 2011)
Most of rhizobacteria belonging to this group are GramnegativerodswithalowerproportionbeingGram-positive rods,cocciorpleomorphic (Bhattacharyya and Jha, 2012) Moreover,numerousactinomycetesarealsooneofthemajor components of rhizosphere microbial communities displaying marvelous plant growth beneficial traits (Bhattacharyya and Jha, 2012; Merzaeva and Shirokikh, 2006).Amongthem,Micromonosporasp.,Streptomycesspp., Streptosporangium sp., and Thermobifida sp., which have shownanenormouspotential asbiocontrol agentsagainst different root fungal pathogens, are worthy of mention (Bhattacharyya and Jha, 2012; Franco-Correa et al., 2) ApplicationofPGPR(PlantGrowth-PromotingRhizobacteria) likeBacillus,Pseudomonas,SerratiaandRhizobiumspp.have showntobebeneficialtocropsandarereportedtoenhance growth and productivity. They are reported to improve germination rateFurther they are found to secrete antibacterial and bio protective compounds which are effective against plant pathogens and pests, facilitate enhanceduptakeofnitrogenandsolubilisationofrecalcitrant phosphorus and its assimilation and production of siderophores to facilitate the absorption of minerals (Herman et al., 2008; Ashrafuzzaman et al., 2009; Richardson et al., 2009).Sugarcaneissensitivetosalinity stress(EC<2dSm-1)andhighsaltlevelsadverselyaffectplant growth.HigherECinhibittherootsfromabsorbingmineral nutrientsleadingtonutrientdeficiency(Sharp and Davies, 2009; Macedo and Jan 2008)
Plantgrowthpromotingrhizobacteriaarethesoil bacteria inhabiting around/on the root surface and are directly or indirectly involved in promoting plant growth and development via production and secretion of various regulatorychemicalsinthevicinityofrhizosphere.Generally, plant growth promoting rhizobacteria facilitate the plant growth directly by either assisting in resource acquisition
(nitrogen,phosphorus,andessentialminerals)ormodulating plant hormone levels, or indirectly by decreasing the inhibitoryeffectsofvariouspathogensonplantgrowthand developmentintheformsofbiocontrolagents.
Variousstudieshavedocumentedtheincreasedhealthand productivityofdifferentplantspeciesbytheapplicationof plantgrowthpromotingrhizobacteriaunderbothnormaland stressedconditions.Theplant-beneficialrhizobacteriamay decrease the global dependence on hazardous agricultural chemicalswhichdestabilizetheagro-ecosystems.

3. MATERIAL AND METHOD
3.1 Sample Collection
Samplingofrootandrhizospheresoilofwheatwascollected fromthefarmofKosadvillage.Amroli,Surathavinglatitude: 21°14’30.1272”N,Longitude:72°51'30.8952"E.Theareawas dividedintothreeblocksandineachofthemonerootsample containingadheredsoilweretakenaroundthreerandomly distributedsmallplants.Allthreesamplesweremixedand filledinplasticbaginaniceboxandcarriedtothelaboratory. Samplewaskeptinrefrigeratorat4°C.
3.1.1 Bacterial Isolation:
Material required:steriledistilledwater,testtubes,pipettes NA media, Petri plates, Flask, Forceps, scalpel, Laminarairflow,Incubator,Soil,androotsampleofWheat,Inoculating loop,Alcohol.
Procedure:
Forrhizospheresoil,clumpofsoillooselyadheringto the roots were removed and one gram of soilsample taken, and sample were added into 10ml of distilled sterilewater,thenserialdilutiondoneupto10-6.
From the 10-6 diluted sample, 0.1ml aliquots were spreadedinpetriplatesofNAmedium.Same2setswere prepared.Theplateswerekeptat37°Cfor24hours.
Parallely,Rootswerewashedundertapwaterfollowed by other wash of distilled water. Roots were cut into smallpieces.
AreaofonePetriplatewasdividedintoeightpartsand ineachpartrootsamplewasinoculated.Likethis,two plateswereprepared.Plateswerekeptforincubationat 37°Cfor24hours.
After observation, distinct colonies are selected and streaked individually on NA plates for the pure or isolated colonies. And subculture was conducted to avoidcrosscontamination.
Plates were stored at 40C after characterization of colonies.Colonymorphologywasdescribedwithspecial emphasis on pigmentation, colony elevation, opacity, etc.
For the bacterial characterization, gram staining technique was performed and observed under light microscope.
3.2 Characterization:
3.2.1 Gram Staining:
Materials Required: Clean glass slides, Inoculating loop Bunsenburner,Bibulouspaper,Microscope,Lenspaperand lens cleaner, Immersion oil Distilled water, 18-to-24-hour culturesoforganisms.
Reagents:
PrimaryStain -CrystalViolet
Mordant -GramsIodine
Decolourizer -EthylAlcohol
SecondaryStain -Safranin
Gram Stain Procedure:
Placeslidewithheatfixedsmearonstainingtray.
Gentlyfloodsmearwithcrystalvioletandletstandfor2 minutes.
Tilttheslideslightlyandgentlyrinsewithtapwateror distilledwaterusingawashbottle.
GentlyfloodthesmearwithGram'siodineandletstand for2minutes.
Tilttheslideslightlyandgentlyrinsewithtapwateror distilled water using a wash bottle. The smear will appearasapurplecircleontheslide.
Decolorizeusing95%ethylalcoholoracetone.Tiltthe slideslightlyandapplythealcoholdropbydropfor5to 10 seconds until the alcohol runs almost clear. Be carefulnottoover-decolorize.
Immediatelyrinsewithwater.
Gentlyfloodwithsafranintocounterstainandletstand for2-3minutes.
Tilttheslideslightlyandgentlyrinsewithtapwateror distilledwaterusingawashbottle.
Blotsdrytheslidewithblottingpaper.
View the smear using a light-microscope under oilimmersion.
3.2.2 Biochemical characterization of root associated soil bacteria and endophytes:
3.2.2.1 Indoleproductiontest
3.2.2.2 Methylredtest
3.2.23 Voges-Proskauertest
3.2.24 Citrateutilizationtest
3.2.2.5 Hydrogensulphideproductiontest
3.2.2.6 CatalaseTest
3.2.27 Oxidasetest
3.2.2.8 Starchhydrolysistest
3.2.2.9 UreaHydrolysistest
3.2.2.10Nitratereductiontest
3.2.2.11CaseinHydrolysistest
3.2.2.12GelatinHydrolysistest
Screening of extracellular enzyme producing microorganisms:
3.2.2.13Amylaseproducer
3.2.2.14Proteaseproducer
3.2.2.15Cellulaseproducer
3.2.2.16Lipaseproducer
3.2.2.17Organicacidproducingmicroorganisms.
3.3 Pot Trial:
Interaction of different potential organic acid producing microbesweredonewithgerminatingmungbeanseed.Total three replication were taken along with control for each isolate at different times interval with different growth parameters like root length, Total protein contents and germinationpercentage.

Germinationpercentage(GP)=seedsgerminated/totalseeds x100.
4. RESULT AND DISCUSSION
4.1 Sample collection:
Sampling of root of size approx. 15-20 cm (plate: 1) and rhizospheresoil(plate:1)ofwheatwascollectedfromthe farmofKosadvillage,Amroli,Surat.
In case of soil associated microbes, 200-300colonies have been observed and from the observed colonies. 15-20 coloniesshowing distinctcharacteristics has been isolated andstreakedfurtheronNAplateandoutof15-20colonies only 4 colonies were showing significant characteristics [Plate3:(MWS1,MWS2,MWS5,MWS6)]



Furtherforthebacterialcharacterization,gramstainingwas performedandobservedunderlightmicroscope(plate: 4) Out of the 4 isolates, MWS-1 was only gram negative remaining three isolates (MWS-2, MWS-5, MWS-6) were found Gram positive (Table: 3). All three Gram positive isolates were rod shaped occurring singly and cluster. WhereasoneGramnegativeisolate(MWS-1)wasshortrod. All4isolatesweremotile.
Incaseofendophyte,fourdistinctcolonies[Plate:5(MWR1, MWR2,MWR3,MWR4)]hasbeenobservedandfurtherGram stainingwasperformedonallfourisolatesbyusingstandard protocol.(Plate:6)
Out of the 4 isolates, MWS-1 was only gram negative remaining three isolates (MWS- 2, MWS-5, MWS-6) were found Gram positive (Table: 4). All three Gram positive isolates were rod shaped occurring singly and cluster. WhereasoneGramnegativeisolate(MWS-1)wasshortrod. All4isolatesweremotile.
Plate 1: CollectionofPotentialisolatefromsoil rhizophereandrootof Triticum aestivum
Bacterial Isolation:
Dilutionofcollectedsampleupto1:1000000ofsoil(MWS) on NAplatesand parallelyinoculated healthy rootsonNA plateskeptfor24hoursofincubationat37C.
Plate 2: IsolationofdifferentPotentialisolatefromsoil rhizophereandrootof Triticum aestivum

Plate
Isolatedpureculturefromsoilof Triticum

Plate
GramstainofisolatedMWS1,

Plate 6: GramstainofisolatedMWR1,






Table -3: Analysisofmorphologicalcharacteristicsofsoil samplebygramstaining Characteristic
Isolatedpureculturefromrootlof Triticum aestivum
Colony
Colony
4.2 Biochemical Characteristics of Root Associated Bacteria:

MWS-6, MWR-2 and MWR-4 were showing positive result towards xylose test, which means that microbe will accumulate acidic by-products. In a positive test, the pH indicatorinthemediumchangescolourfromitsnormalred toyellow,indicatingacidproduction.MWS-5,MWR-1,MWR2, and MWR-3 were showing positive response towards sucrose test which means Bacteria were identified based largely on what organic compounds they can break down. Therangeofcompoundsuseddependsonthecollectionof enzymesaspeciesofbacteriacanmake.OnlyMWS-5,MWR-I andMWR-3wereshowingpositiveresulttowardsmannitol test which means that they can ferment the carbohydrate (sugar)mannitolasacarbonsource.MWS-1,MWS-5,MWR-1, MWR-2,andMWR-3wereshowingpositiveresulttowards maltose test which means that they can ferment the carbohydrate (sugar) maltose as a carbon source. MWS-2. MWS-5, MWR-1 and MWR-2 were showing positive result towardsfructosetestwhichmeansthattheycanfermentthe carbohydrate(sugar)fructoseasacarbonsource.
Colonies of MWS-1.MWS-2 was showing urea production whichmeansthatmicrobecanusethecompoundureaasa source of carbon and energy for growth. Use of urea is
accomplished by the enzyme urease. MWS-5 and MWR-3 were showing positive results towards gelatine hydrolysis testwhichmeansthattheyhaveabilitytoproducegelatinase thatliquefygelatinetopolypeptidesandaminoacid.MWS-1, MWS-2,MWS-5,MWS-6,MWR-1,MWR-2,MWR-3,andMWR4wereshowingpositiveresulttowardglucoseuptakewhich is important source for C and N that help in promoting various metabolism.MWS-1 and MWS-2 were showing positive result towards indole test which determine the abilityoforganismtoconverttryptophanintoindole.MWS-5, MWR-1andMWR-2wereshowingresponsetowardscitrate testwhichmeansthattheyhaveabilitytousecitrateasthe sole source of carbonand energy. All the isolated colonies wereshowingpositiveresponsetowardscatalasetest,which meansthattheseorganismshaveabilitytoproducecatalase that detoxicity H2O2 by breaking it into H2O and oxygen. MWS-1,MWS-2MWS-5andMWR-1wereshowingpositive response towards nitrate reduction, which means that bacteria have ability to reduce nitrate which further help them in defence mechanism. MWS-S and MWR-1 were showing positive response towards starchdegradation,by whichIwasabletodifferentiatespeciesfromthegenerasuch as clostridium and bacillus. MWS-6 and MWR-4 were showingpositiveresulttowardsMRtest,whichhelpmeto detectPHalongwith,whichfermentationpathwayisusedto utilize glucose. MWS-1, MWS-5, MWR-1, and MWR-2 were showingpositiveresponsetowardslactosetest,whichmeans thatmicrobescanfermentcarbohydrate-lactoseasacarbon source.OnlyMWR-1wasshowingpositiveresulttowardsVP test which means that they were producing acetyl methyl carbinolfromglucosefermentation.Inwhich,acetylmethyl carbinolisconvertedtodiacetylinthepresenceα-naphthol, strongalkaliandatmosphericoxygen(Table-5&Table-6)
Table -5: Biochemicalcharacterizationofrootassociated soilbacteriaandendophyte.
4.3
FurtherPotstudieswerecarriedouttoassessthegrowthand biochemical changes in Vigna radiate (Mung bean) after inoculatingitwithIsolatesMWS5andMWR3.Treatedseeds wereallowedtogerminateinpetriplates atdifferenttime interval, (12hr,24hr.48hr,76hr.96hr) while uninoculated mungbean seed serve as control (MWS-5C & MWR-3C). However, it was observed that Vigna radiata plants inoculated with MWS-5 exhibited significant increment of rootgrowthofabout29mm,51.33mm,53mm,58mmattime intervalof24hr.,48hr.,72hr.,andat96hr.whencompared
with control MWS-5 C, increment of root length of about 23.66mm,46.33mm,50.66mm,56.33mm.Similarly,MWR3 alsoexhibitedsignificantincrementofrootofabout30mm, 54.33mm,51.66mm,54.33mmrespectivelyattimeintervalof 24hr.,48hr,76hr andat96hr,whencomparedwithcontrol MWR3 C, show increment of root length of about 24mm, 46.66mm,46mm,46mm,50.33mm(Table-7&Table-8)
Table -7: RootlengthofMWS5atdifferenttimeinterval.

Table -8: RootlengthofMWS3atdifferenttimeinterval.
Estimation Of Protein Content:
In case of protein content-on the basis of Fowling lowery methoditwasobservedthatVignaradiataplantsinoculated with MWS-5 exhibited significant increment of protein concentration of about 7.449mg/ml, 9.058mg/ml,
11.085mg/ml & 14.354mg/ml at time interval of 24 hr,48hr,72hr and at 96 hr., when compared with control MWS-5C,whichshowincrementofproteinconcentrationof about 5.013mg/ml, 7.2851mg/ml, 10.071mg/ml & 13.831mg/ml. similarly MWR-3 also exhibited significant increment of protein concentration of about 7.765mg/ml, 8.456mg/ml,12.341mg/mland15.927mg/mlrespectivelyat time interval of 24hr., 48hr., 76hr., and at 96hr., when comparedwithcontrolMWR-3C,showincrementofprotein content of about 6.675mg/ml, 7.847mg/ml, 10.157mg/ml and14.907mg/ml(Table-9)












Table -9: EstimationofproteinactivityofMungbeanat differenttimeinterval.

After
Plate 6: Germinationofmungbeanseedatdifferenttime interval.







Table -10: Germinationpercentageofmungbeanat differenttimeinterval.

A. Germinationpercentageofmungbeanafter12hours
B. Germinationpercentageofmungbeanafter24hours
C. Germinationpercentageofmungbeanafter48hours
D. Germinationpercentageofmungbeanafter72hours
E. Germinationpercentageofmungbeanafter96hours

5. CONCLUSIONS
Wheatisagrasswidelycultivatedforitsseed,acerealgrain which is a worldwide staple food. Wheat crop has wide adaptability.Itcanbegrownnotonlyinthetropicalandsubtropicalzones,butalsointhetemperatezoneandthecold tracts of the far north beyond even the 60-degree north altitude.Microbesintherhizosphereareinvolvedinmany processes that determine agricultural soil productivity, includingpreservationofsoil structure,nutrientrecycling, diseasecontrolanddegradationofpollutants.
Onbasisofmorphologicalandbiochemicalcharacterizations, isolates were identified as MWS1 (nitrobactor sp), MWS2 (nitrosomonas.), MWS5 (Bacillus sp.) and MWS6 (acetobacter)respectivelyasrootassociatedsoil microbes and isolate MWR1, MWR2, MWR3, MWR4 name like as Bacillus subtillis pseudomonas, bacillus sp., acetobater respectivasendophytes.FurtherPotstudieswerecarriedout toassessthegrowthandbiochemicalcomponentsofVigna radiate.Seedsweretreatedwithtwopotentialisolatesviz.as Bacillus cereus strain MWS5 and bacillus flexus MWR3 exhibited significant increment in root growth as well as proteincontentatdifferenttimeintervali:eupto58mmas comparedtorootgrowthofcontrolofMWS5-Cwhichexhibit rootgrowthofabout56.33mmandproteincontentisabout 14.354mg/ml of MWS5 as compared to protein content of control (MWS5-C) which was about 13.831. Similarly, mungbean inoculated with MWR3 show Significant incrementinrootlengthofapprox54.33mmascomparedto MWR3-Cwhichshowrootgrowthofabout50.33mm.aswell as protein content is about 15.927mg/ml of MWR3 as comparedtoproteincontentofcontrol(MWR3-C)whichwas about14.831mg/ml.
So,fromalltheaboveobservationandresultobtained,itcan be concluded thatthesepotential isolates could befurther studied for metabolic profiling for identification and quantificationoforganicacidandfieldtrail.
6. REFERENCES
[1] Antoun,H.,&Prévost,D.(2005).Ecologyofplantgrowth promoting rhizobacteria. In PGPR: Biocontrol and Biofertilization(pp.1-38).Springer.
[2] Ashrafuzzaman,M.,Hossen,F.A.,Ismail,M.R.,Hoque,M. A.,Islam,M.Z.,&Shahidullah,S.M.(2009).Efficiencyof plant growth-promoting rhizobacteria (PGPR) for the enhancement of rice growth. African Journal of Biotechnology,8(7),1247-1252.
[3] Antoun,H.,&Prévost,D.(2005).Ecologyofplantgrowth promoting rhizobacteria. In PGPR: Biocontrol and Biofertilization(pp.1-38).Springer.
[4] Ashrafuzzaman,M.,Hossen,F.A.,Ismail,M.R.,Hoque,M. A.,Islam,M.Z.,&Shahidullah,S.M.(2009).Efficiencyof plant growth-promoting rhizobacteria (PGPR) for the enhancement of rice growth. African Journal of Biotechnology,8(7),1247-1252.
[5] Bergersen, F. J. (1971). Symbiotic nitrogen fixation in legumesandsomeotherplants.AdvancesinAgronomy, 23,1-44.
[6] Deepa,C.K.,Thakur,A.,&Singh,D.(2010).Isolationand characterization of efficient phosphate solubilizing bacteriafromsoilsamplesofvegetablefieldsofBihar. AfricanJournalofMicrobiologyResearch,4(22),23722377.
[7] Dey.R., Pal, K.K., Bhatt, D.M.,and Chauhan,S.M.(2004).Growth promotion and yield enhancement of peanut (Arachishypogaea L.) by application of plant growth promoting rhizobacteria. 10.1016/j.micres.2004.08.004Microbiol.Res.159,371394.doi:
[8] Elliott,L.F.,Gilmour,C.M.,Lynch,J.M.,andTittermore,D. 1984. Bacterial colonization of plant roots. ASA Spec. Publ.47:1-16.
[9] Figueiredo, M. V. B., Burity, H. A., Martinez, C. R., & Chanway,C.P.(2011).Alleviationofdroughtstressin the common bean (Phaseolus vulgaris L.) by coinoculationwithPaenibacilluspolymyxaandRhizobium tropici.AppliedSoilEcology,48(2),157-164.
[10] Glick,B.R.(1995).Theenhancementofplantgrowthby freelivingbacteria.Can.J.Microbiol.4,1109-1114.
[11] Gray.E.J.,and Smith,D.L.(2005). Intracelluler and extracellular PGRP: commonalities and distinctions in the plant-bacterium signaling processes. Soil Biol. Biochem. 37, 395-412.doi: 10.1016/j.soilbio.2004, 08.030.
[12] Herman,M.A.,Farag,M.A.,&Wainscott,M.R.(2008). Biological seed treatments. In Principles of plantmicrobeinteractions(pp.415-425).Springer,Cham.
[13] Jeon.J.S.. Lee, S.S., Kim, H.Y., Ahn, T.S..andSong. H.G. (2003). Plant growth promotion in soil by some inoculatedmicroorganisms.J.Microbiol.41,271-276.
[14] Kloepper, J. W. 1993. Plant growth-promoting rhizobacteria as biological control agents. In Soil microbial technologies. Edited by. Metting. Marcel Dekker,Inc.,NewYork.pp.255-274.
[15] Kloepper, J. W. (2003). Plant growth-promoting rhizobacteria as biological control agents. In Soil

microbiology,ecology,andbiochemistry(pp.221-236). AcademicPress.
[16] Kumar, A., Maurya.B.R., and Raghuwanshi, R. (2014). IsolationandcharacterizationofPGPRandtheireffect on growth, yield, and nutrient content in wheat (Triticum aestivum L.). BiocatalAgricBiotechnol.3,121128.
[17] Macedo, V. R., & Jan, A. (2008). Effect of salinity on growth and yield of sugarcane. Journal of Agronomy, 7(3),221-232.
[18] Marques, J. M., da Silva, T. F., Vollu, R. E., Blank, A. F., Ding,G.C.,&Seldin,L.(2010).Plantgrowthpromoting rhizobacteria from wheat, maize and sorghum root microbiomes exhibiting different abilities to suppress Moniliophthoraperniciosa,thecausalagentofwitches' broomdiseaseofcocoa.JournalofMicrobiology,48(6), 785-791.
[19] Marques,A.P.G.C.,Pires,C.,Moreira,H.,Rangel,A.O.S.S., andCastro.P.M.L.(2010).Assessmentoftheplantgrowth promotion abilities of six bacteria liso- latesusing Zeamaysasindicatorplant.SoilBiol.Biochem.42.12291235.doi:10.1016/j.soilbio.2010.04.014
[20] Mehnaz, S., Baig, D. N., Lazarovits, G., & Punja, Z. K. (2010).Pseudomonasspp.andtheirinteractionswith crops.CanadianJournalofPlantPathology,32(4),497506.
[21] Mendes,R.,Kruijt,M.,deBruijn,I.,Dekkers,E.,vander Voort,M.,Schneider,J.H.,&Raaijmakers,J.M.(2011). Deciphering the rhizosphere microbiome for diseasesuppressivebacteria.Science,332(6033),1097-1100.
[22] Mirza,M.S.,Rasul,G.,Mehnaz,S.,Ladha,J.K.,So,R.B.,Ali, S., etal. (2000). "Beneficial effects of nitrogen-fixing bacteriaonrice."inTheQuestforNitrogenFixationin Rice,edsJ.K.LadhaandP.M.Reddy(LosBaños:IRRI),191204.
[23] Muneshwar, S., V.P. Singh, K.S. Reddy, and M. Singh. 2001.Effectofintegrateduseoffertilizernitrogenand farmyardmanureorgreenmanureontransformationof N,KandSandproductivityofrice-wheatsystemona Vertisol.J.Ind.Soc.SoilSci.,49:430-435.
[24] Narula,N.,Kumar,V.,Behl,R.K.,&Dudeja,S.S.(2005). EstablishmentofAzotobacterasbioinoculantformaize using enriched FYM. Journal of Agricultural Research, 41(4),325-333.
[25] Oerke,E.C.(2006).Croplossestopests.TheJournalof AgriculturalScience,144(1),31-43.
[26] Ozturk, A., Tüzel, Y., & Gozubenli, H. (2003). Effect of plantgrowth-promotingrhizobacteriaonyoungapple tree growth and fruit yield under orchard conditions. JournalofPlantNutrition,26(7),1291-1302.
[27] Panke-Buisse,K.,Poole,A.C.,Goodrich,J.K.,Ley,R.E.,& Kao-Kniffin, J. (2015). Selection on soil microbiomes reveals reproducible impacts on plant function. The ISMEjournal,9(4),980-989.
[28] Patel, H.; Jadav, C. and Kalaria, R. (2017). Biochemical and Molecular Profiling of Novel Halophiles Isolated from Coastal Region of South Gujarat, Trends in Bioscience.10(1):368-378.
[29] Richardson,A.E.,Barea,J.M.,McNeill,A.M.,&PrigentCombaret, C. (2009). Acquisition of phosphorus and nitrogenintherhizosphereandplantgrowthpromotion bymicroorganisms.PlantandSoil,321(1-2),305-339.
[30] Sahin,F.,Cakmakci,R.,andKanta,F.(2004).Sugarbeet andbarleyyieldsinrelationtoinoculationwithN2-fixing andphosphatesolubilizingbacteria.PlantSoil265,123129.doi:10.1007/s11104-005-0334-8.
[31] Shaharoona, B., Arshad, M., Zahir, Z. A., & Khalid, A. (2008). Performance of Pseudomonas fluorescens as inoculant on growth and yield of wheat (Triticum aestivum L.) in the presence of different levels of nitrogen.JournalofAgriculturalResearch,46(3),217224.
[32] Sharp,R.E.,&Davies,W.J.(2009).Hormonesandsalt stress.NewPhytologist,181(3),571-571.
[33] Somasegaran, P., & Hoben, H. J. (1994). Handbook for rhizobia: Methods in legume-rhizobium technology. SpringerScience&BusinessMedia.
[34] Somers, E., Vanderleyden, J., & Srinivasan, M. (2004). Rhizospherebacterialsignalling:aloveparadebeneath ourfeet.Critical Reviewsin Microbiology,30(4),205240.
[35] Tan,Z.X.,&Tan,T.K.(1986).Theeffectsofinoculating therootsystemofpeanutswithBradyrhizobiumstrains onyieldandquality.PlantandSoil,92(1),105-112.
[36] Timm, C. M., Campbell, A. G., Utturkar, S. M., Jun, S. R., Parales, R. E., Tan, W. A., & Doktycz, M. J. (2016). MetabolicfunctionsofPseudomonasfluorescensstrains from Populus deltoides depend on rhizosphere or endosphere isolation compartment. Frontiers in Microbiology,7,17.
[37] Vessey, J. K. (2003). Plant growth promoting rhizobacteria as biofertilizers. Plant and Soil, 255(2), 571-586.

[38] Weston, D. J., Pelletier, D. A., Morrell-Falvey, J. L., Tschaplinski,T.J.,Jawdy,S.S.,Lu,T.Y.S.,&Martin,M.Z. (2012). Pseudomonas fluorescens induces straindependentandstrain-independenthostplantresponses in defense networks, primary metabolism, photosynthesis, and fitness. Molecular Plant-Microbe Interactions,25(6),765-778.
[39] Zamioudis,C.,Mastranesti,P.,Dhonukshe,P.,Blilou,I.,& Pieterse,C.M.(2013).Unraveling root developmental programs initiated by beneficial Pseudomonas spp. bacteria.PlantPhysiology,162(1),304-318.

[40] Zhang,Y.F.,Wu,X.Q.,Chen,W.P.,&Chen,B.D.(2012). Inoculation with phosphate-solubilizing bacteria and nitrogen-fixingbacteriaalleviatesthegrowthinhibition ofmaize(ZeamaysL.)causedbyhighconcentrationsof ammoniumnitrogen.AppliedSoilEcology,61,264-270.
BIOGRAPHIES
MonalibenLalitbhaiPansuriya (B.sc.AgriculturalBiotechnology)

